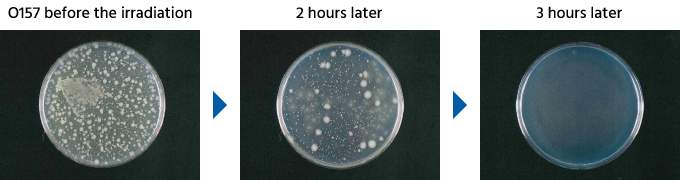
Streamer: efecto de eliminación frente a la cepa O157 con una unidad Streamer
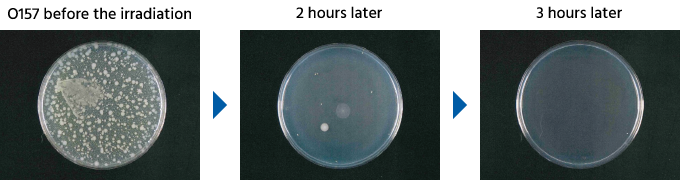
Streamer: efecto de eliminación frente a la cepa O157 con dos unidades Streamer

Demostración del efecto de eliminación frente a la cepa O157
Funcionamiento de una unidad Streamer
Funcionamiento de dos unidades Streamer
Organización encargada de las pruebas
Japan Food Research Laboratories
Método de prueba
Irradiando la cepa O157 con la unidad Streamer durante 1, 2, 3, 4, 8 horas e inoculando cultivos de células, observamos el estado residual de la cepa O157 mediante la diferencia en el tiempo de irradiación de la unidad Streamer.

El índice de supervivencia de la cepa O157 después de 2 horas de irradiación con Streamer fue del 0,1% con dos unidades funcionando frente al 1,8% con una unidad funcionando, lo que confirma que la eliminación fue 18 veces más efectiva. Además, después de 3 horas, se confirmó que el efecto de eliminación fue del 99,9% tanto con dos unidades funcionando como con una.
* Los resultados se han obtenido solamente de un dispositivo de descarga Daikin Streamer en condiciones experimentales.
O157 con toxina agresiva e infecciosa
La cepa O157 produce una toxina agresiva denominada Verotoxina, que provoca dolor abdominal, diarreas con sangre y vómitos. Es una de las bacterias más nocivas y puede provocar síntomas graves y muertes cuando niños o ancianos resultan contagiados. Además, el riesgo de contagio es muy alto. En general, la intoxicación alimentaria solo se desarrolla cuando "cerca de 1 millón" de bacterias invaden, mientras que la cepa O157 produce intoxicación alimentaria incluso con un número pequeño de "cerca de 100" bacterias.
